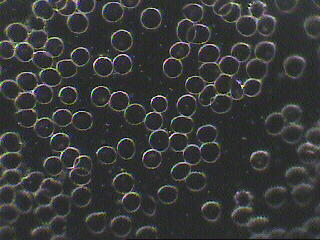

Dunkelfelddiagnose - Naturheilpraxis Stauner-Rubeck II
Hauptmenü:
Unser Angebot > Diagnostik

Dunkelfelddiagnostik
Ein Verfahren zur Früherkennung und Diagnostizierung von Regulationsstörungen, Stoffwechselstörungen, Erkrankungen einfacher und komplexer Art sowie zur Therapiekontrolle. Im Dunkelfeld lässt sich das zu untersuchende Material wesentlich besser und detaillierter erkenn als im Hellfeld. Bei der Betrachtung des Kapillarblutes im Dunkelfeld kann man an Hand der Zellendarstellung und sich weiteren zeigenden Phänomene Hinweise entnehmen, die auf das Vorhandensein bestimmter Erkrankungen, Störungen oder Krankheitstendenzen im Organismus hinweisen. Chronische Übersäuerungen, Organschwächen, zellulärer Sauerstoffmangel, Allergien, Probleme des Immunsystems, Stoffwechselprobleme bei Störungen von Darm, Leber, Nieren und anderer Organe sind die erkennbaren Zeichen der Dunkelfelddiagnostik.
Der deutsche Professor Dr. Günther Enderlein, Zoologe und Entomologe hatte diese Methode in den 1920er Jahren entwickelt. Sein Gedanke bzw. Theorie des Pleomorphismus von Bakterien d.h. dass die Bakterien bzw. auch Pilze ein vielgestaltiges Wachstum zeigen und zur Entstehung von Krebs führen, sorgte zwar für größeres Aufsehen, jedoch setzte sich das Konzept des Monomorphismus von Ferdinand Cohn durch. Ebenso wurde der Monomorphismus in der medizinischen Biologie durch die Arbeiten von Louis Pasteur und Robert Koch als grundlegende Lehrmeinung durchgesetzt.
Die primitiven Vorstufen der Pilzarten Mucor racemosus und Aspergillus niger spielen nach Enderlein bei allen Säugetieren als Symbionten eine besondere Rolle.
Nach seiner Pensionierung verlegte Enderlein seine Tätigkeit in die Pharmazie und war Produktionsleiter beim Pharmaunternehmen Sanum.
Ganz gleich wie eine Diskussion verläuft, Tatsache ist, dass die herkömmliche und allein anerkannte Blutuntersuchung im Labor ein Messverfahren darstellt und eine Dunkelfelduntersuchung am lebenden Blut stattfindet und andere Bewertungskriterien ermöglicht. Wichtig ist was erfahrungsgemäß letztendlich für das Wohlbefinden des Menschen herauskommt.
Links zu Informationen von Enderlein:Wikipedia
Dunkelfeldmikroskopie Bericht von HP Bärbel Hoffmeister
Home | Über uns | Unser Angebot | Veranstaltungen | Preise | Links | Kontakt | Impressum | Generelle Seitenstruktur